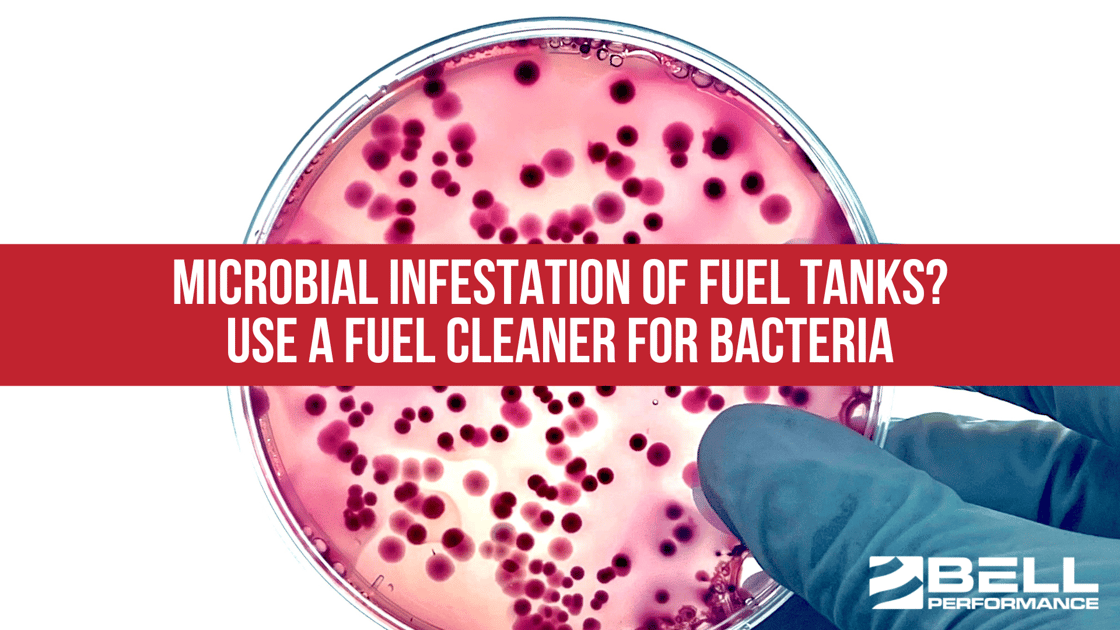
Microbial Infestation of Fuel Tanks? Use a Fuel Cleaner for Bacteria

1 min read
Why Is Preventive Fuel Maintenance Critical for Your Stored Fuel Today?
The concept of preventive maintenance isn't new—we see it everywhere in our daily lives. You change your car's oil before it breaks down. You...
2 min read
Bell Performance : Apr 9 2024
Anyone who stores or distributes fuel, including your local gas station, has “issues” with controlling and preventing the growth of bacteria and fungi (“microbes”) in their fuel tanks. Think your local place is immune? Think again. Anywhere there is water (and since fuel tanks are vented to the outside air, there’s *always* water), you have a situation where microbes can grow and multiply in the tank – bacteria and fungi need water build-up to grow and thrive. If your fuel supplier or gas station has a microbial issue, you could have one too – it’s very easy for those microbes to get transferred to your vehicle’s fuel tank, growing and multiplying until you have the same kind of problems your supplier had - clogged fuel filters, corroding tanks and performance-robbing buildup of deposits (caused by the acids the microbes excrete which cause fuel to break apart and lose combustion quality).
Fuel suppliers spend significant amounts of time and money each year trying to keep the problem of microbial contamination in fuel under control. An infected storage tank can choke off the lifeblood of their business – consumer confidence in the quality of their fuel - not to mention get them shut down if a fuel inspector drops by and discovers the problem.
There are many fuel treatment products in the marketplace that claim to eliminate bacteria by removing water or controlling its buildup. All is not what it seems there. To prevent bacterial infection of tanks, you do have to keep water build-up under control (with Florida’s humid climate year-round, that’s a tall order for Florida businesses). Even then, however, it's not a guarantee.
Once microbes do establish themselves in a fuel system, simply removing the water will not be enough to kill and remove the infestation – they can still hang around in the fuel tank or live within the biofilms they produce on internal surfaces, waiting for water to accumulate again so they can begin their lifecycles anew. Any product that claims to destroy and remove an infection simply by controlling water accumulation is not telling the whole truth. To get rid of the fuel infection for good (and the problems that go with it), you need to use a fuel biocide to disinfect the tank and kill the microbes for good.
Biocides are very tightly regulated by the EPA (and for good reason). The reason many of these products try to get away with making "biocidal claims" without actually being biocides is that it's expensive to comply with the safety regulations biocides are required to follow. Those regulations are there for a reason.
Most biocides are quite powerful with low treatment rates (1 ounce to 80 gallons or more). Keep in mind, though, that not all microbial contaminations are the same. Even the best biocides might require a follow-up application to completely knock out the microbial problem.
Concerned about microbes and bacteria and want to keep your fuel cleaner? Call us at 877-231-6673 to learn more about Bellicide.

1 min read
The concept of preventive maintenance isn't new—we see it everywhere in our daily lives. You change your car's oil before it breaks down. You...
1 min read
Maintaining today's stored backup fuels is a bigger job than it used to be. One major reason is that fuels themselves have changed. Ultra-low sulfur...
1 min read
A diesel storage tank rarely fails on a Monday morning with no warning. The signs build up quietly. Filter changes start running short....